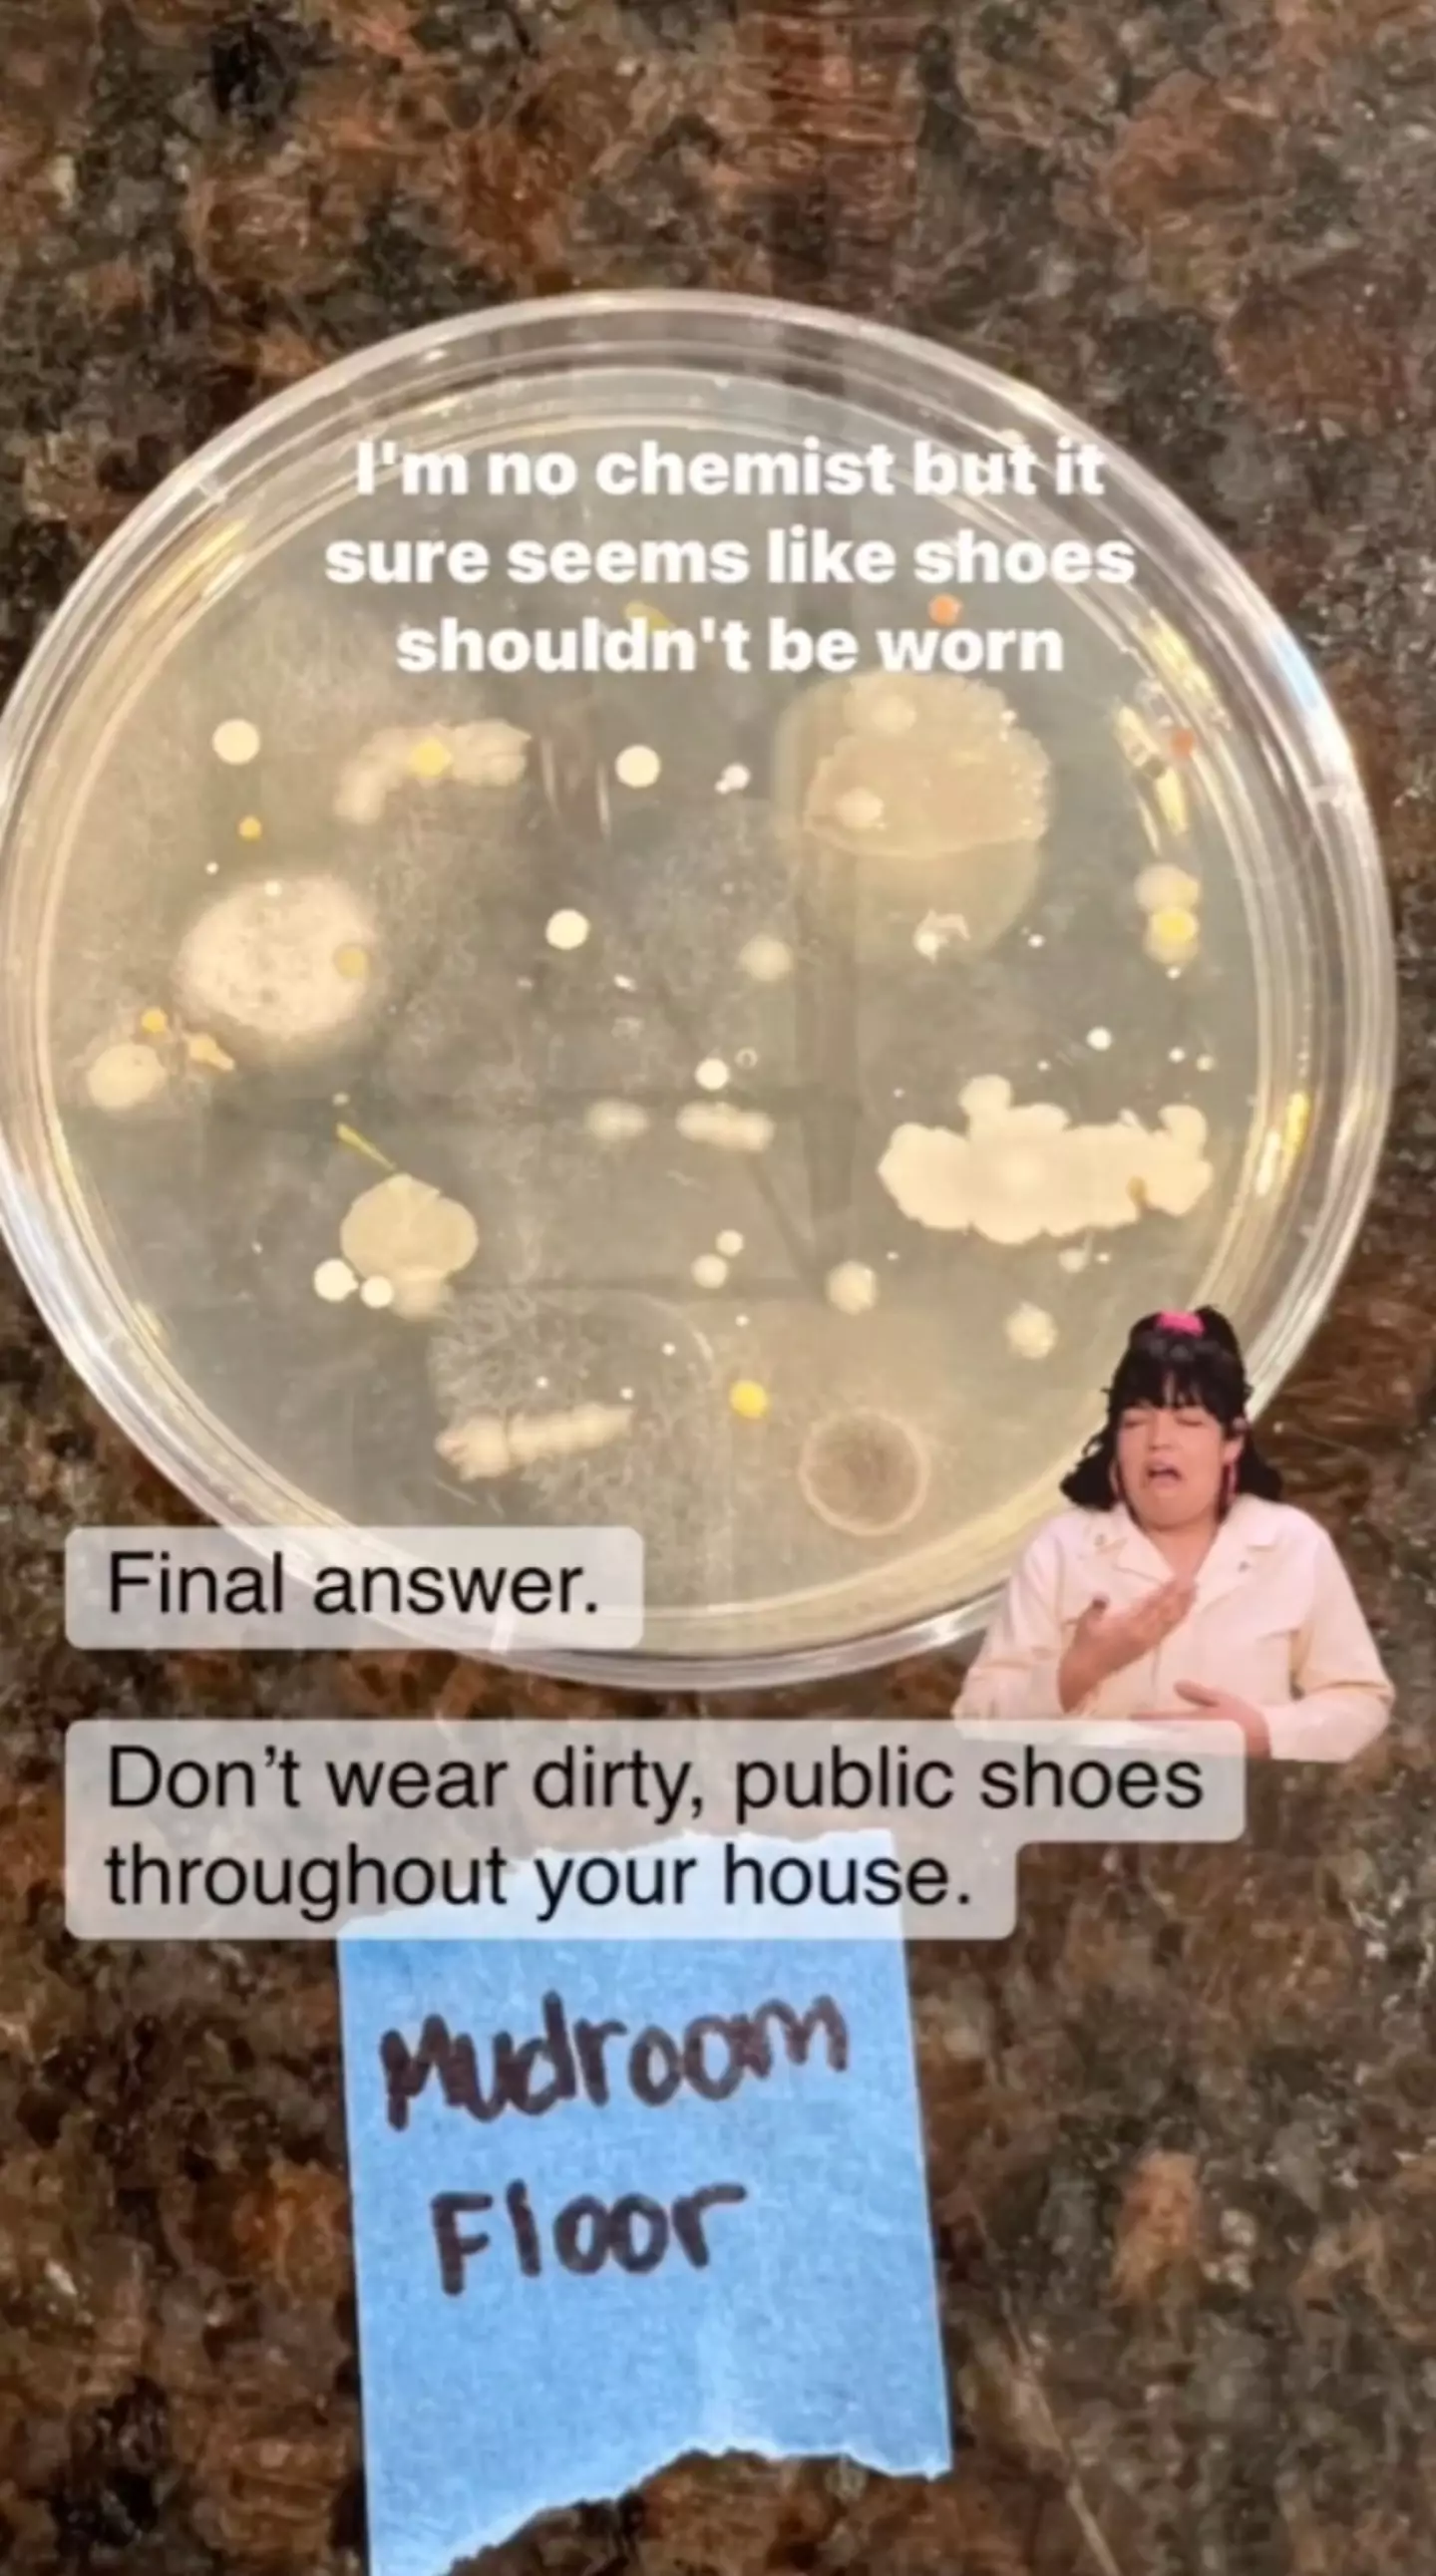

We're all guilty of spending a day, or night, walking about town, parks and just about everywhere in between and forgetting to take off our outdoor shoes at the front door.
Well, one expert has since revealed a harrowing reason why you should never wear outdoor shoes inside the house and it's pretty disgusting if you ask me.
Cleaning aficionado, Dena O’Neill, took to Instagram to show her followers exactly why the golden rule must not be broken under any circumstances. Check it out but - heads up - it's super gross:
Dena began the short clip confirming: "I'm not a chemistry teacher, but I think you'll find the results at the end very interesting."
That they were.
Advert
She continued: "There's a common argument between many people to wear shoes that you wear in public through your house or not."
The cleaning expert revealed she was definitely on team 'don't wear your shoes in the house' but was shocked to find out just how many people argued that it was really 'no big deal'.
So, without further ado, Dena set out to 'find the answer'.
In the Instagram reel, Dena swabbed the bottom of her shoe and then she swabbed the floor of the 'mudroom', which is the only floor in her home that shoes are 'actually worn'.
Advert
Dena then wiped the swab on petri dishes and left them 'undisturbed for a week in a dark closet'.

"This is what grew," she said showing a nauseating concoction of bacteria build-up festering on one of the petri dishes.
The woman concluded: "I'm no chemist, but it sure seems like shoes shouldn't be worn in your house."
Advert
I'm not arguing with that.
Dena captioned the Instagram reel: "These petri dishes have me shook."
Us too, Dena, us too.
In the caption, she added: "While I can’t tell you exactly what’s growing in those dishes, I have to assume it’s not good bacteria cause well…let me list some of the places we walk."
Advert
"Such places include; parks, where animals pee and poop, grass, where animals pee and poop, public restrooms, where people pee and poop then flush with no lid so the 'PLOOM OF POO' flies up into the air and then to the floor and lastly, floors where other people wear their public shoes and who knows where they’ve walked and traveled."
With that in mind, it's no wonder that Dena extends the rule beyond just her family.
"Oh and yes, I make guests take them off too [...] and if they can’t (workers or something), I have shoe covers available."
Advert
Dena resolved: "Here’s the thing, if you’re wearing these shoes through your house, you have to clean your floors WAY MORE OFTEN. That takes way longer than taking off the shoes.
"If you have to wear shoes, get a pair that don’t go outside of your home and switch into those to keep your feet comfy but your floors cleaner for longer."
Guess we all got to stock up on some slip-ons.